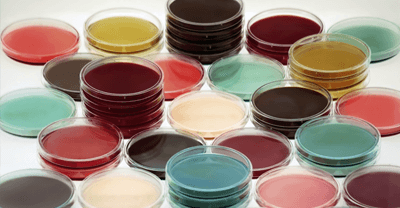
Microbiology: accredited or customized methods?

Thanks to 20 years of experience in the field of applied microbiology, we can support our customers in the analysis of their probiotic-based products in every step of the supply chain, from the production of the raw material to the evaluation of the shelf-life of the finished product. The list of our accredited analyzes is available on the Accredia website on the page relating to our laboratory but the laboratory is able to apply any protocol provided by the customer in order to obtain the best product performance.
Each analysis requested to our laboratory is carefully planned and studied by our technicians, whether it is a normalized method or a protocol proposed by the customer.
We evaluate the most appropriate method to be applied to each strain or to the mixture of strains, according to customer's needs. We share with you the strategy to be followed before even drawing up the estimate.

We are able to perform genetic and functional typing for the preparation of a scientific dossier on your strains, as raw materials or finished product that you plan to put on the market.

AAT is the first European laboratory to have accredited the MIC (minimum inhibitory concentration) determination of antibiotics, i.e. the method indicated by EFSA for the determination of antibiotic resistance in bacterial strains.

We support the entire food supplement chain with flow cytometric analysis, according to ISO 19344: 2010, providing valuable information on the viability of cells in raw materials and finished products.